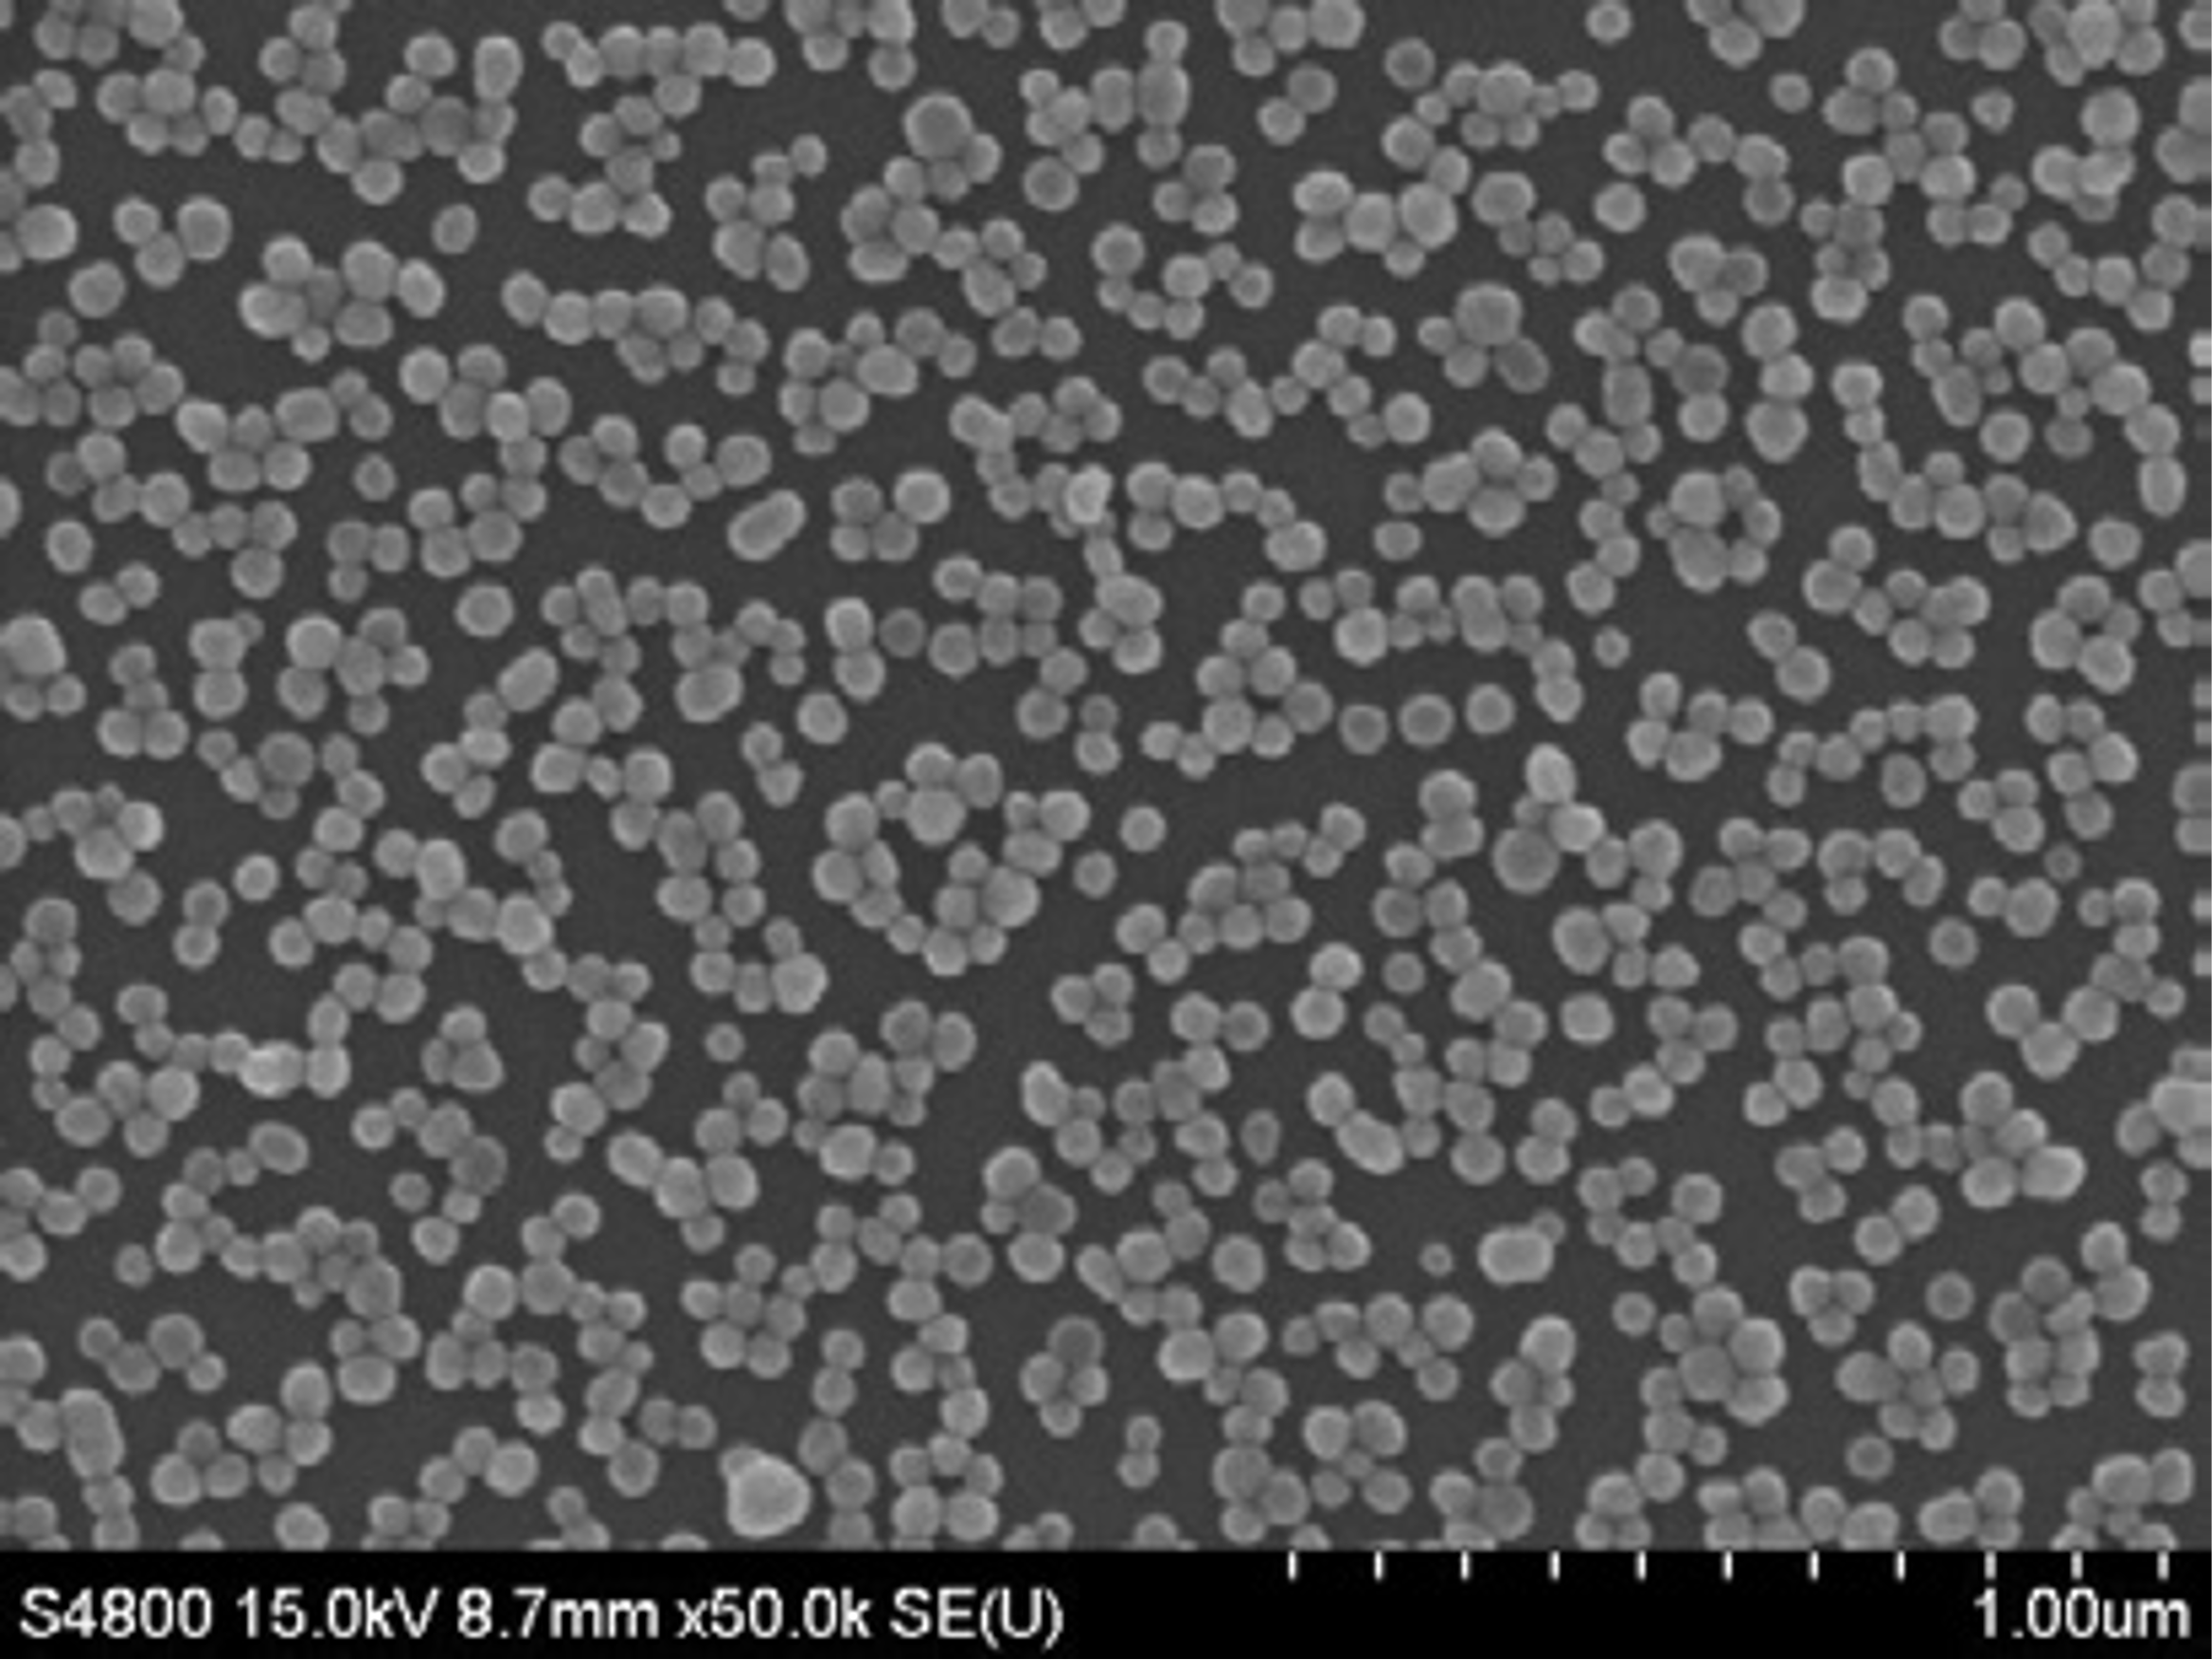
65e93838b8b9a.png 65e93838b8b9a.png

cy888彩运 > 溶胶型SERS增强试剂CP-S3

溶胶型SERS增强试剂CP-S3
CP-S3为银纳米粒子溶胶型增强试剂,比金纳米粒子具有更优异的拉曼增强效果,提升了产品性能,大大拓展了产品应用范围,除适用于对色素、添加剂等有机化学物种的SERS检测,还适用于弱吸附分子如山梨酸和苯甲酸的检测。
.jpg)
【产品简介】
溶胶型SERS增强试剂CP-S3为银纳米粒子溶胶型增强试剂,比金纳米粒子具有更优异的拉曼增强效果,提升了产品性能,大大拓展了产品应用范围,除适用于对色素、添加剂等有机化学物种的SERS检测,还适用于弱吸附分子如山梨酸和苯甲酸的检测。
【产品特点】
★产品组分: 银纳米粒子溶胶
★粒径范围:40~60 nm
★吸收峰位置:401±2 nm
★粒子浓度(Particles / ml):4.0 E+11
★溶剂:0.01% 柠檬酸盐溶液
★规格:20 ml、60 ml、100 ml(可根据需求提供其他规格)
.jpg)
下一个:
溶胶型SERS增强试剂CP-1


